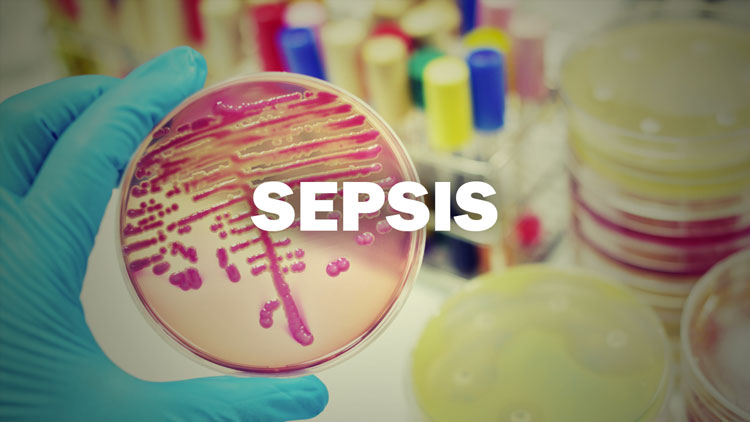

What is Clinical Pearls?
Clinical Pearls is a bi-weekly podcast from the University of Alabama at Birmingham (UAB) School of Nursing. Faculty and other health care leaders share their expertise and educational resources while discussing current topics.
-
Nov. 19, 2024
Beyond the Battlefield
Dr. Randy Moore is a dedicated health care leader specializing in Veteran health and well-being. As a Veteran himself, he focuses on bridging gaps in health care knowledge related to the unique needs of America’s Veteran population.
Oct. 29, 2024Heart to Heart
Join us for a conversation with Dr. Carla Turner, a heart failure certified nurse practitioner and supervisor at UAB’s Heart FailuRe Transitional Care Services for Adults (HRTSA) Clinic, a nurse-managed interprofessional collaborative clinic for underserved patients with a diagnosis of heart failure.
Oct. 15, 2024Navigating Dementia
On this episode, Dr. Rita Jablonski discusses preventing and navigating Frontotemporal Dementia, and how she blends clinical research with clinical practice, offering persons with dementia and their caregivers the best of both worlds.
Oct. 1, 2024Bridging Gaps
Join us as Dr. Timiya S. Nolan discusses community-driven cancer research and the importance of researcher-community collaboration. Marcus Glover will also share details about the Hey Fellows program, a unique initiative bridging the gap between research and community needs.
Sep. 17, 2024The AI Clinic: Where Tech Meets Care
Join us for a conversation with Chris Hickman, a seasoned data analyst with nearly two decades of experience. As the founder of Blueline Insights, he's leveraged data analytics and AI to drive business solutions across various industries. His passion for AI and continuous learning has led him to join the UABSON faculty, where he shares his knowledge of informatics and AI with students and faculty.
Sep. 3, 2024Bones and Beyond
Join us for a fascinating discussion with Dr. Andrea Boohaker, Associate Vice President of Ambulatory Services at UAB. With over 17 years of experience in orthopedic trauma, Dr. Boohaker is a leading expert in the field. Prior to her current role, she helped expand APP services at the busiest trauma center in the country.
Jun. 4, 2024Fun in the Sun
Summer is a great time to be outdoors, but it's important to be prepared to stay safe and healthy. Tune into this episode as we hear from Dr. Jeremy Jordan and Alexandra Armstrong share their tips for beating the heat while still having fun in the sun.
May 21, 2024Practice Makes Perfect
On this episode, Dr. Penni Watts discusses improving patient safety through innovative training methods. Her contributions to simulation and nursing education excellence have focused on the development, implementation and evaluation of evidence-based standards to guide practice and growing leaders in using simulation as a learning modality.
May 7, 2024Empowering Nurse Leadership
Prior to joining the faculty at UAB, Dr. Greg Eagerton was a nurse and Chief Nursing Officer for 31 years in the Veterans Health Administration before retiring in October 2017. As Chief Nursing Officer and Interim Chief Executive Officer in VHA hospitals, he led over 3,000 employees and the operations providing care for over 70,000 Veterans.
Apr. 23, 2024Improving Lives Through the Nurse-Family Partnership
On this episode, Dr. Karmie Johnson and Dr. Candace Knight talks to us about the goals of the UAB Nurse-Family Partnership (NFP), including improved pregnancy outcomes by helping women engage in good preventive health practices.
Apr. 9, 2024Using Generative AI in the Classroom
On this episode, Dr. Amy Chatham, Director of the Center for Teaching and Learning at UAB, discuss innovative ways to integrate AI tools into teaching practice while addressing ethical considerations.
Mar. 26, 2024Pressure Points: Navigating Intraoperative Hypotension Challenges
On this episode, Dr. Amy Yerdon discusses how low blood pressure during surgery is common in patients having non-cardiac surgery under general anesthesia. This can be secondary to many factors but has been linked to major postoperative complications.
Mar. 12, 2024Painful Inequalities: The Epigenomic Factor
Dr. Edwin Aroke is a Certified Registered Nurse Anesthetist (CRNA) and a Nurse Scientist whose program of research focuses on racial pain disparities. His program of research, which is funded by the NIH, examines the role of epigenomic changes on chronic pain and pain disparities.
Feb. 27, 2027Medically Guided Weight Loss: Separating Fact from Fiction
On this episode we are joined by Britney Nguyen, a women’s health nurse practitioner who is a graduate of the UAB School of Nursing and currently works in a women’s health clinic that also specializes in weight loss management. She joins to enlighten us on the emergence of prescription weight loss industry.
Feb. 13, 2024Birth After Transplant: Exploring Uterine Transplantation
On this episode we are joined by Emily Boydston, the only dedicated uterus transplant coordinator in the country. Emily is a graduate of the UAB School of Nursing and currently serves as the uterus transplant coordinator at UAB Medicine.
Jan. 30, 2024State of the Nation's Emergency Departments
On this episode, Dr. Melanie Hallman, who has been a leader in emergency services for over four decades, will discuss reasons for and possible solutions to reducing overcrowding in our emergency departments.
Jan. 16, 2024STOP THE BLEED® and Save a Life
On this episode, Dr. Allison Jones talks to us about the goals of the STOP THE BLEED® campaign and how to better prepare the public to save lives by raising awareness of basic actions that can stop life threatening bleeding following everyday emergencies and man-made and natural disasters.
Jan. 2, 2024The Mind Unraveled
On this episode, Dr. Rita Jablonski talks to us about a specific kind of dementia, Behavioral Variant Frontotemporal dementia (bvFTD), that is the second most common cause of young onset dementia after Alzheimer's disease.
Dec. 19, 2023Let’s All Get Along
On this episode, Dr. Brian Flanagan, a pulmonologist and critical care physician, and Adam Weekley, an ICU nurse and nurse practitioner student, discuss ways they have achieved optimal communication techniques.
Dec. 5, 2023Your Voice Matters
On this episode, Dr. Eileen Meyer, a nurse practitioner and the Assistant Director to Advanced Practice Providers at UAB Medicine, discusses how nurses have the potential to profoundly influence policy on a global scale.
Nov. 21, 2023Combating Human Trafficking
On this episode, Dr. Lauren Mays, a Family Nurse Practitioner who maintains a clinic practice at the Well House, discusses ways to combat human trafficking through a trama-informed care lens.
Nov. 7, 2023Phone a Friend
On this episode, Paul Malito, Nurse Manager for UAB’s TeleICU, discusses how telehealth helps to accomplish two key goals for inpatient care: proactively addressing changing patient conditions and making more efficient use of experienced nurses’ knowledge.
Oct. 24, 2023Maternity Care Deserts
On this episode, Dr. Elizabeth Munoz, a certified Nurse-Midwife and Co-Director of the UABSON MSN Nurse-Midwifery Pathway, talks to us about the critical role nurse midwives play in providing avenues that improve access to health care services improves the overall health status of a community.
-
Dec. 2, 2022
Nurse Practice Act for RN & Advanced Practice
Guest panelists: Natalie Baker, DNP and Elizabeth Crooks, DNP
Learn more about the laws for governing nurse practice.
Nov. 4, 2022Doctor of Nursing Practice Degree
Guest panelists: Curry Bordelon, DNP and Terri Poe, DNP
Translate knowledge for improvements in clinical practice.
Oct. 7, 2022Adult-Gero Nurse Practitioner
Guest panelists: Cori Johnson, DNP and Rebecca Suttle, DNP
Become an Adult-Gero Acute or Primary Care Nurse Practitioner.
Sep. 2, 2022Nursing Health System Leadership
Guest panelists: Greg Eagerton, DNP and Marisa Wilson, DNSc
Hone your skills for management and executive leadership in healthcare organizations.
Aug. 5, 2022Choosing your Graduate Clinical Nursing Path
Guest panelists: Curry Bordelon, DNP and Tedra Smith, DNP
Expand your horizons in nursing fields.
June 3, 2022Nurse Scientist: Into Tomorrowland
Guest panelists: Sigrid Ladores, PhD and Ellen Smith, PhD
Discover knowledge to change healthcare.
May 6, 2022Midwifery: Call the Midwife
Guest panelists: Sharon Holley, DNP and Allison Shorten, PhD
Impact the lives of mothers, babies and families.
Apr. 1, 2022Pediatrics: Toy Stories
Guest panelists: Jeremy Jordan, PhD and Tedra Smith, DNP
Learn about advanced pediatric nursing practice: ambulatory and acute.
Mar. 4, 2022Nurse Anesthesia: While You Were Sleeping
Guest panelists: Edwin Aroke, PhD and Susan McMullan, PhD
Specialize in nurse anesthesia perioperative practice.
Feb. 4, 2022Entry Into Practice: Great American Heroes
Guest panelists: Katie Parris, DNP, Michael Mosley, DNP and Danielle Baker, DNP
Explore the different options to becoming a nurse.
Nov. 5, 2021COVID's Burden on Nursing
Guest panelists: Susanne Fogger, DNP, Teena McGuinness, PhD and Paula Levi, BSN (PhD Student)
Our guests will discuss the effects of caring for patients on bedside nurses and the ramifications of the COVID pandemic on nursing practice.
Oct. 1, 2021Clinical Challenges Due to COVID
Guest panelists: Stuart Cohen, MD and Turner Overton, MD
This show will feature a discussion about long-term patient outcomes and other clinical challenges in the fight against COVID.
Sep. 3, 2021Reducing the Spread of Covid
Guest panelists: Ian Moore, DVM, Ellen F. Eaton, MD and Suzanne E. Judd, PhD
Our panelists will discuss how healthcare providers and public health officials have addressed issues concerning vaccines and other measures to promote health and safety during the COVID pandemic.
Aug. 6, 2021Effects of COVID on Mental Health
Guest panelists: Marcus Debiasi, DDS, Erica Kierce, DNP and Karmie Johnson, DNP
Our featured guests on this show are psychiatric nurse practitioners who will discuss how the COVID pandemic has affected the mental health of adults and children
Jun. 4, 2021Caring for Homeless Patients
Guest panelists: Richard Taylor, Phd and Jennifer Janowiecki, MSN
Guests for this episode will share their experiences in caring for homeless patients and discuss how to meet the diverse needs of this vulnerable population.
May 7, 2021Care of Children in School Settings
Guest panelists: Jasmine Barnett, MSN and Tanya Kendrick, BSN
This episode will feature a discussion between nurses who care for children in K-12 settings about how to address challenges in ensuring optimum care for all children.
Apr. 2, 2021Caring for LGBTQ+ patients
Guest panelists: Michelle Allen, Ed.D and Meghan Whitfield, CRNP
Our panelists will discuss how to meet the needs of LGBTQ+ patients using culturally competent care.
Mar. 5, 2021Caring for Military and Veteran Patients
Guest panelists: Linda S. Schwartz, DrPH and Patricia Patrician PhD
This discussion between national nurse leaders will focus on caring for active military patients and veterans in various settings.
Feb. 5, 2021Caring for Diverse Populations
Guest panelists: Marisa Wilson DNSc, Nancy Rudner, DrPH and Karyn Nicholson, DNP
Our guests will discuss strategies for reducing healthcare disparities among diverse populations to optimize patient outcomes.
Dec. 4, 2020Animal-assisted Therapy
Guest panelists: Meredith Guthrie, MSN, Kiersten Atkinson, Amy Hamilton, Stacey Roudebush and Pam Strange from Hand in Paw
Join us to learn how introducing animal-assisted therapy affects a patient's emotional and social well-being in the intensive care unit.
Nov. 6, 2020Resilience & Coping Skills for Healthcare Providers
Guest panelists: Whitney Pollio, EdD, Pariya Wheeler, PhD and Casey Azuero, PhD
Healthcare providers are used to taking care of others, but how can they best take care of themselves? Our panelists will discuss skills that can be developed for resilience and coping, especially during times of extreme stress.
Oct. 2, 2020Healing Arts
Guest panelists: Kimberly Kirklin, MA, Salaam Green, MEd and Wesley Hyde, MT-BC
Our panelists from the UAB Arts in Medicine group will discuss how they encourage healing by engaging patients in creative arts such as music therapy, poetry, visual arts, and more.
Sep. 4, 2020Assessing and Treating Common Sports Injuries
Guest panelist: Bryan Combs, PhD
Dr. Combs will discuss common sports injuries and provide helpful hints for evaluating and treating them.
Mar. 6, 2020Care Transitions
Guest panelists: Alison Garretson, MBA
In this episode, we will learn about effective care transitions: Preventing medical errors, identifying issues for early intervention, preventing unnecessary hospitalizations and readmissions, supporting consumer preferences and choices, and avoiding duplication of processses and efforts to more effectively utilize resources.
Feb. 7, 2020Quality & Safety
Guest panelist: Rebecca S. Miltner, PhD
Nursing quality and safety are important topics in acute care, academic, and other organizational settings. Join us for this episode to learn how bedside nurses play an active role in improving the quality and safety of patient care.
Dec. 6, 2019Women’s Health Across the Lifespan
Guest panelist: Aimee Holland, DNP
In this episode, Dr. Holland will discuss reproductive planning counseling, preventive services, and office gynecology procedures.
Oct. 4, 2019Sex Trafficking
Guest panelist: Ashley Hodges, PhD
Dr. Hodges will address the topic of violence against women, women's health and empowerment during this show.
Jun. 19, 2020Using Telehealth during the COVID-19 Pandemic to Meet the Needs of Vulnerable Populations
Guest panelists: Deborah Bowers, DNP, Candace Knight, PhD and Michele Talley, PhD
Our guests will discuss how their clinics are using telehealth to meet patients' healthcare needs during the COVID-19 pandemic.
Sept. 6, 2019Reducing Sepsis Mortality
Guest panelist: Mary Grace Cox, MPH
Reducing the incidence of sepsis is an institutional priority for Health Systems. Mary Grace Cox, the UAB Sepsis Coordinator, will share why sepsis is a common issue and how to develop a protocol.
Jul. 12, 2019Trauma Informed Care
Guest panelist: Patricia Speck, DNSc
Trauma Informed Care (TIC) begins with the assumption that all nurses have trauma backgrounds. TIC interventions improve quality and safety, and promote disclosure during nursing assessments for planned patient-centered care.
Jun. 7, 2019Beyond Electronic Health Records
Guest panelist: Marisa Wilson, DNSc
What is informatics or more specifically nursing informatics? How does technology affect patient privacy and electronic health records? This episode will address these questions and more--a topic of interest for patients and caregivers.
May 3, 2019Veteran-centric Care: Focus on Mental Health
Guest panelist: Teena McGuinness, PhD
Dr. Teena McGuinness identifies psychiatric nursing issues that pertain to Veterans and goes over resources for nurses and caregivers.
Apr. 5, 2019Waking Up to Obstructive Sleep Apnea
Guest panelist: Karen Heaton, PhD
Dr. Karen Heaton will address the effects of sleep deprivation and obstructive sleep apnea on cognition and injury risk in workers.
Mar. 1, 2019Stop the Bleed
Guest panelist: Allison Jones, PhD
In this episode, will discuss the identification of life-threatening bleeding, and appropriate application of bleeding control methods based on the location of the wound.
Feb. 1, 2019Common Conditions in Children During the Winter Months
Guest panelist: Tedra Smith, DNP
In this episode, we will discuss winter warning signs that need immediate attention, and address the topics of fever, antibiotics, vaccines, OTC medications and more.
Jul. 13, 2018Managing Dementia in Acute and Long-term Care Settings
Guest panelist: Rita Jablonski, PhD
The goal for this segment is to improve the hospital experience for people with dementia. People with dementia demonstrate challenging behaviors when hospitalized; these behaviors are their way of communicating. We will discuss basic ways to decode the messages.
Aug. 3, 2018Managing Care for Patients with Heart Failure
Guest panelist: Dana Mitchell, DNP
Heart failure is characterized by the heart's inability to pump an adequate supply of blood. Let's examine the symptoms, causes, and treatments with Dr. Mitchell.
Sep. 7, 2018Patient Education and Insulin Management
Guest panelist: Michele Talley, PhD
In this episode, we will learn about the impact that patient education and nurse decision-making have on patients taking insulin.
Oct. 5, 2018Recognizing Acute Myocardial Infarction in Women
Guest panelist: Grace Grau, DNP
Learn the 6 heart attack symptoms common in women--treatment, causes, diagnosis, and prevention.
Nov. 2, 2018Referring Patients to Palliative Care Services
Guest panelist: Richard Taylor, PhD
Palliative care places importance on the individual's needs and wishes, but talking about death and dying can be stressful. Health professionals can make a difference when a referral is made early. Tune in and learn more with Dr. Taylor.
Jun. 1, 2018The Changing Face of the Opioid Epidemic
Guest panelist: Susanne Fogger, DNP
In this episode, we will identify signs of opioid addiction and provide resources for clinicians at the bedside.